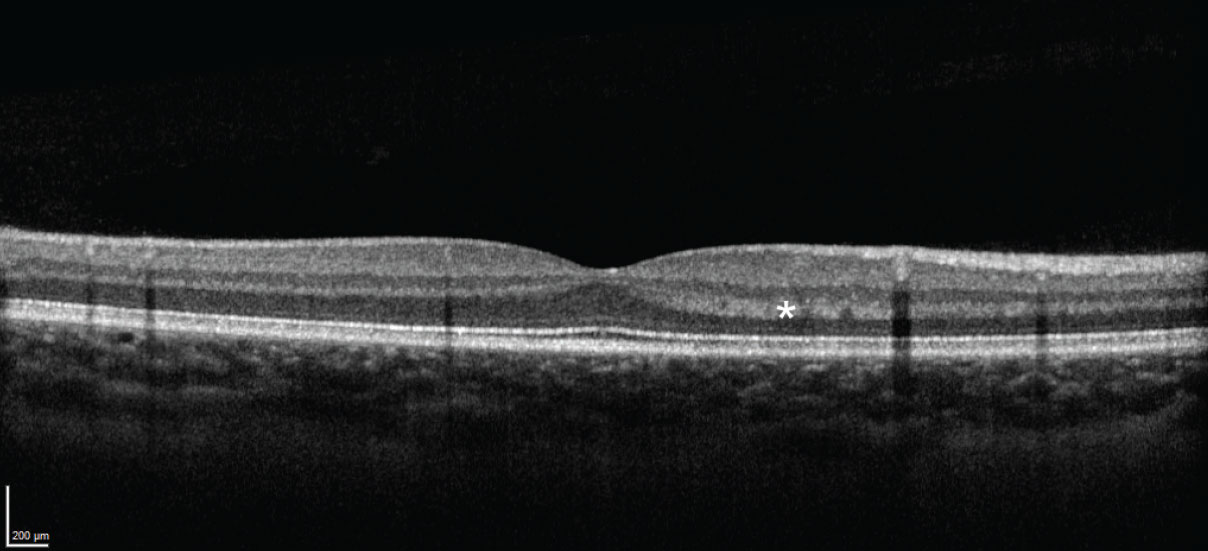

|
| Nikhil Bommakanti, MD |
|
Bio Dr. Bommakanti is a vitreoretinal surgery fellow at Wills Eye Hospital/Mid Atlantic Retina, Philadelphia. |
A 16-year-old female with no past medical or ocular history presented with flashes, gray dots and blurred vision in both eyes for one day.
Workup and imaging
Snellen visual acuity was 20/25 in the right eye and 20/20 in the left eye. Intraocular pressures were normal in both eyes. Anterior segment examination was normal. There were no cells in the anterior chamber or the anterior vitreous of either eye.
Funduscopic examination of both eyes demonstrated clear vitreous and normal optic discs (Figure 1). Subtle wedge-shaped gray lesions were noted in the macula of both eyes. The vessels and periphery were normal.
Optical coherence tomography of both eyes demonstrated multiple areas of outer retinal hyperreflectivity spanning the Henle fiber layer through the interdigitation zone and sparing the retinal pigment epithelium in both eyes (Figure 2).
Diagnosis
Our differential diagnosis for this patient included acute macular neuroretinopathy, acute posterior multifocal placoid pigment epitheliopathy, laser-induced maculopathy and contusion maculopathy. The absence of RPE involvement was inconsistent with APMPPE and laser-induced maculopathy, and there was no history of laser exposure or trauma. Furthermore, the patient’s visual symptoms began three days after an upper respiratory illness.
We diagnosed this patient with AMN based on the clinical history, examination and the OCT findings, particularly the striking HFL hyperreflectivity.
 |
|
Figure 1. Ultra-widefield fundus images of both eyes demonstrate subtle wedge-shaped gray lesions in the macula of both eyes. |
Discussion
AMN typically occurs in one or both eyes of young women. One review of 156 eyes from 101 cases demonstrated 54 percent were bilateral, 84 percent occurred in women and the median age was 26 years.1
Risk factors include a preceding viral illness, use of oral contraceptives, use of epinephrine or ephedrine, hypovolemia, pregnancy and excessive caffeine intake, which suggest AMN results from vascular compromise.1 Note that the association with oral contraceptive use is confounded by the fact that this condition commonly occurs in young women, therefore the decision whether to discontinue these medications should be individualized. Our patient did have a preceding febrile illness and was using oral contraceptive medications. Most patients present with one or more scotomas. Photopsia and blurred vision, as in this case, can also occur.1
AMN was initially described in the pre-OCT era.2 Since then, OCT has emerged as an invaluable tool for diagnosing, managing and understanding this condition.
 |
|
Figure 2. OCT of both eyes demonstrated multiple areas of outer retinal hyperreflectivity spanning the Henle fiber layer through the interdigitation zone and sparing the retinal pigment epithelium, in both eyes. |
This patient demonstrated striking hyperreflective changes involving multiple areas of the HFL in both eyes (Figure 2). The HFL comprises photoreceptor axons and Müller cell outer processes, and is oriented radially because the inner retinal elements migrate peripherally while the outer retinal elements migrate centrally during retinal development. This provides a less obstructed path for light and concentrates cones centrally.3 The radial pattern is why, for example, neuroretinitis classically demonstrates a macular star.
The HFL is typically difficult to distinguish from the outer nuclear layer on standard spectral domain-OCT because both layers are hyporeflective.4
The HFL can appear hyperreflective due to alterations in either: 1) the angle of incident light or 2) the structure of the HFL itself.5,6 The first can occur due to slight variations in the orientation of the patient’s eye or changes in the orientation of the retina itself, such as with subretinal or sub-RPE pathology (Figure 3).4 The second can occur when material, such as hemorrhage or exudate, accumulates in the HFL, or when the HFL itself is disrupted.
Features of the angular sign of HFL hyperreflectivity
New York retina specialist Prithvi Ramtohul and colleagues recently introduced the OCT terminology “angular sign of HFL hyperreflectivity” (ASHH) to describe disruption of the entire length of photoreceptors, which appears as a hyperreflective lesion extending from the Henle fiber layer to the interdigitation zone.7 Note that ASHH (an OCT finding) isn’t exclusive to AMN (a medical condition). The differential for ASHH includes APMPPE, acute retinal pigment epitheliitis, autoimmune retinopathy, contusion maculopathy and laser-induced maculopathy, among others.7 Yet ASHH can be useful in making the diagnosis—and may shed light onto the pathogenesis—of AMN.
|
|
Figure 3. Normal OCT image from a different eye, demonstrating hyperreflectivity of the Henle fiber layer resulting from the orientation of the incident light. |
ASHH occurs early in AMN then rapidly fades, and is followed by classic OCT features of AMN, including thinning of the ONL and disruption of the ellipsoid zone and interdigitation zone.8,9 In fact, in our patient, ASHH was present one day after symptom onset, and had already begun to fade one week later, at which point disruption of the EZ and IZ became more prominent (Figure 4).
The source of vascular compromise in AMN (insufficiency of the retinal versus the choroidal circulation), was previously debated, however work using OCT angiography10 as well as this sequence of events, where HFL abnormalities precede deeper outer retinal changes without involving the RPE, implicate deep capillary plexus ischemia as the cause of AMN. This mechanism contrasts that of photic retinopathy, in which energy absorption by the RPE results in anterograde photoreceptor disruption, as well as APMPPE, in which choroidal abnormalities result in pathologic changes, including disruption of the RPE.
 |
|
Figure 4. Optical coherence tomography image of the left eye at presentation (A) and one week later (B) demonstrating reduced prominence of the Henle fiber layer hyperreflectivity and more prominence of the ellipsoid and interdigitation zone disruption, along with outer nuclear layer thinning. The lesions are well-visualized on near-infrared images (left). |
Paracentral acute middle maculopathy, or inner nuclear layer infarction due to ischemia of the intermediate and deep (and sometimes superficial) capillary plexuses, can also cause hyperreflectivity on OCT.10 However this occurs in the INL (and may extend into the outer plexiform layer) and results in INL thinning over time, whereas hyperreflectivity and disruption in AMN involves the OPL, HFL, ONL, EZ and IZ and results in ONL thinning over time (recall this is due to damage to the photoreceptors).11 Furthermore, PAMM differs from AMN in that PAMM is an OCT finding that should prompt a search for the underlying cause (similar to how cotton wool spots, when observed, should prompt further evaluation), whereas AMN is a retinal disease.12 While PAMM can coexist with AMN,12 the OCT in this case demonstrated the absence of inner retinal pathology.
Note that ASHH may be more common than we previously recognized, and it may be missed because 1) it fades early and 2) the HFL is radially oriented, so horizontal B-scans on OCT may not capture it.7,9
Treatment and prognosis
Treatment involves addressing underlying causes if any are found. In the review cited previously, at final follow-up, more than 80 percent of patients had a visual acuity of 20/40 or better, however 53 percent had persistent scotomas. In our experience, some patients with persistent scotomas may not notice them unless they look closely for them. AMN can recur, but this is uncommon.
Bottom line
AMN typically affects one or both eyes in young women and should be on the differential diagnosis in such patients. ASHH can be an early finding in AMN and supports the hypothesis that this disease results from ischemia to the deep capillary plexus. Most patients have good visual acuity, but many will have persistent scotomas. RS
1. Bhavsar KV, Lin S, Rahimy E, et al. Acute macular neuroretinopathy: A comprehensive review of the literature. Survey of Ophthalmology. 2016;61:5:538-565.
2. Bos PJ, Deutman AF. Acute macular neuroretinopathy. Am J Ophthalmol. 1975;80:4:573-584.
3. Hendrickson AE, Yuodelis C. The morphological development of the human fovea. Ophthalmology. 1984;91:6:603-612.
4. Mrejen S, Gallego-Pinazo R, Freund KB, Paques M. Recognition of Henle’s fiber layer on OCT images. Ophthalmology. 2013;120:6:e32-33.e1.
5. Otani T, Yamaguchi Y, Kishi S. Improved visualization of Henle fiber layer by changing the measurement beam angle on optical coherence tomography. Retina. 2011;31:3:497-501.
6. Lujan BJ, Roorda A, Knighton RW, Carroll J. Revealing Henle’s fiber layer using spectral domain optical coherence tomography. Invest Ophthalmol Vis Sci. 2011;52:3:1486.
7. Ramtohul P, Cabral D, Sadda S, Freund KB, Sarraf D. The OCT angular sign of Henle fiber layer (HFL) hyperreflectivity (ASHH) and the pathoanatomy of the HFL in macular disease. Progress in Retinal and Eye Research. 2023;95:101135.
8. Fawzi AA, Pappuru RR, Sarraf D, et al. Acute macular neuroretinopathy: Long-term insights revealed by multimodal imaging. Retina. 2012;32:8:1500-1513.
9. Bommakanti N, Young BK, Johnson MW, Miller JML. Optical coherence tomography angular hyperreflectivity as an early sign in acute macular neuroretinopathy. Canadian Journal of Ophthalmology. Published online August 2023:S0008418223002405.
10. Chu S, Nesper PL, Soetikno BT, Bakri SJ, Fawzi AA. Projection-resolved OCT angiography of microvascular changes in paracentral acute middle maculopathy and acute macular neuroretinopathy. Investigative Ophthalmology & Visual Science. 2018;59:7:2913-2922.
11. Scharf J, Freund KB, Sadda S, Sarraf D. Paracentral acute middle maculopathy and the organization of the retinal capillary plexuses. Prog Retin Eye Res. 2021;81:100884.
12. Rahimy E, Kuehlewein L, Sadda SR, Sarraf D. Paracentral acute middle maculopathy: What we knew then and what we know now. Retina. 2015;35:10:1921.



